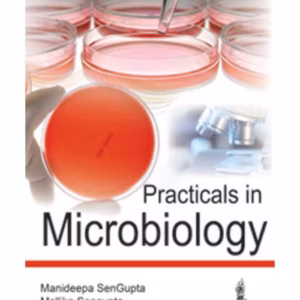

The book is divided into five sections and each topic is explored in in great detail in each of these sections: Aspects of Hearing Loss, Assessment of Cochlear Implant Candidacy, The Cochlear Implant/Surgical Procedures, Results and Outcomes of Cochlear Implantation, and Current Concepts and Future Technology.
Cochlear Implants: Principles and Practice – Medical Textbook
₹10,969.00
28% Off
Close
Price Summary
- ₹15,235.00
- ₹10,969.00
- 28%
- ₹10,969.00
- Overall you save ₹4,266.00 (28%) on this product
In Stock
Highlights:
- ISBN – 9781787791190
- Author – David S Haynes
- Edition – 1st Edition
- Publisher – Jaypee Brothers Publisher
- Year – 2020
- Binding – Hardbound
- Language – English
Ask a Question
Ask a Question
40 People viewing this product right now!
Additional information
| Weight | 0.5 kg |
|---|---|
| Dimensions | 8.5 × 11 × 2 cm |
| Edition | 1st Edition |
| Author | David S Haynes |
| ISBN | 9781787791190 |
| Language | English |
| Year | 2020 |
| Binding | Hardbound |
| Publisher | Jaypee Brothers Publisher |
| Pages | 264 |
Reviews (0)

There are no reviews yet.